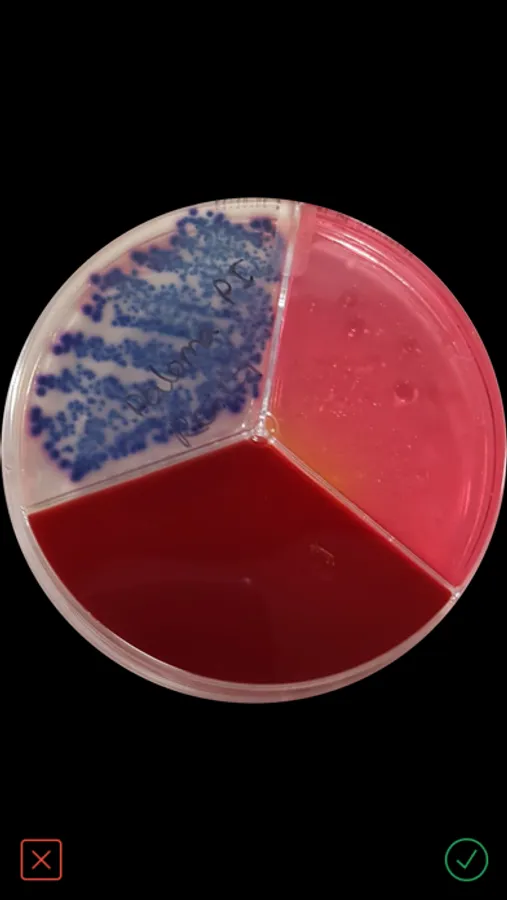
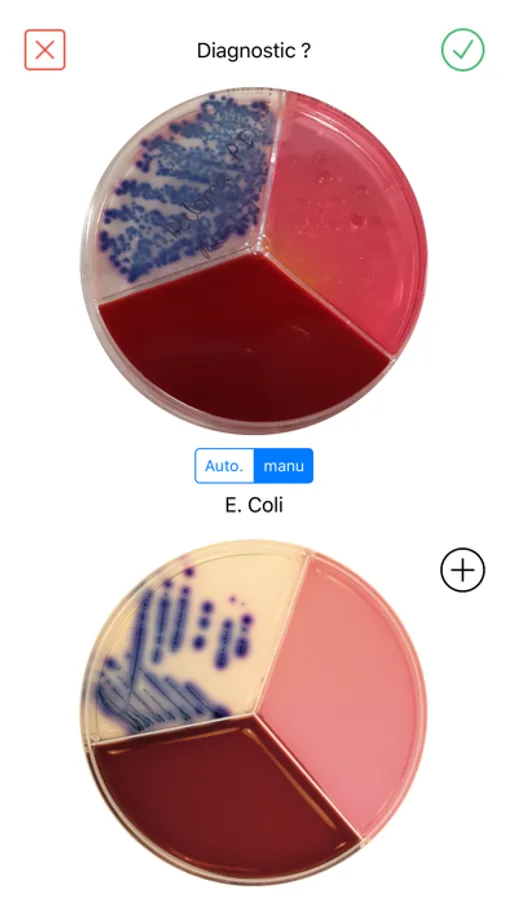

About Vetorapid
Using a picture of a VetoRapid plate, it helps you to confirm the pathogen(s) and establish a quick and adapted treatment.
Based on the initial input of experts enriched by deep learning functionality, the system provides an automatic reading of a Vetorapid plate.
If the user does not agree with the automatic reading, he can override it and make a manual diagnostic.
VetoRapid app can use pictures taken by the user and pictures received in his smartphone through mail or any other messaging systems.
With VetoRapid app the dairy practitioner saves time and gains precision in prescribing the most adapted treatment, while contributing to build a valuable benchmark with each diagnostic.
VetoRapid app is available in most major European languages
To get an activation QR code please contact your Vetoquinol Territory Manager
Based on the initial input of experts enriched by deep learning functionality, the system provides an automatic reading of a Vetorapid plate.
If the user does not agree with the automatic reading, he can override it and make a manual diagnostic.
VetoRapid app can use pictures taken by the user and pictures received in his smartphone through mail or any other messaging systems.
With VetoRapid app the dairy practitioner saves time and gains precision in prescribing the most adapted treatment, while contributing to build a valuable benchmark with each diagnostic.
VetoRapid app is available in most major European languages
To get an activation QR code please contact your Vetoquinol Territory Manager
Vetorapid Screenshots
Tap to Rate: